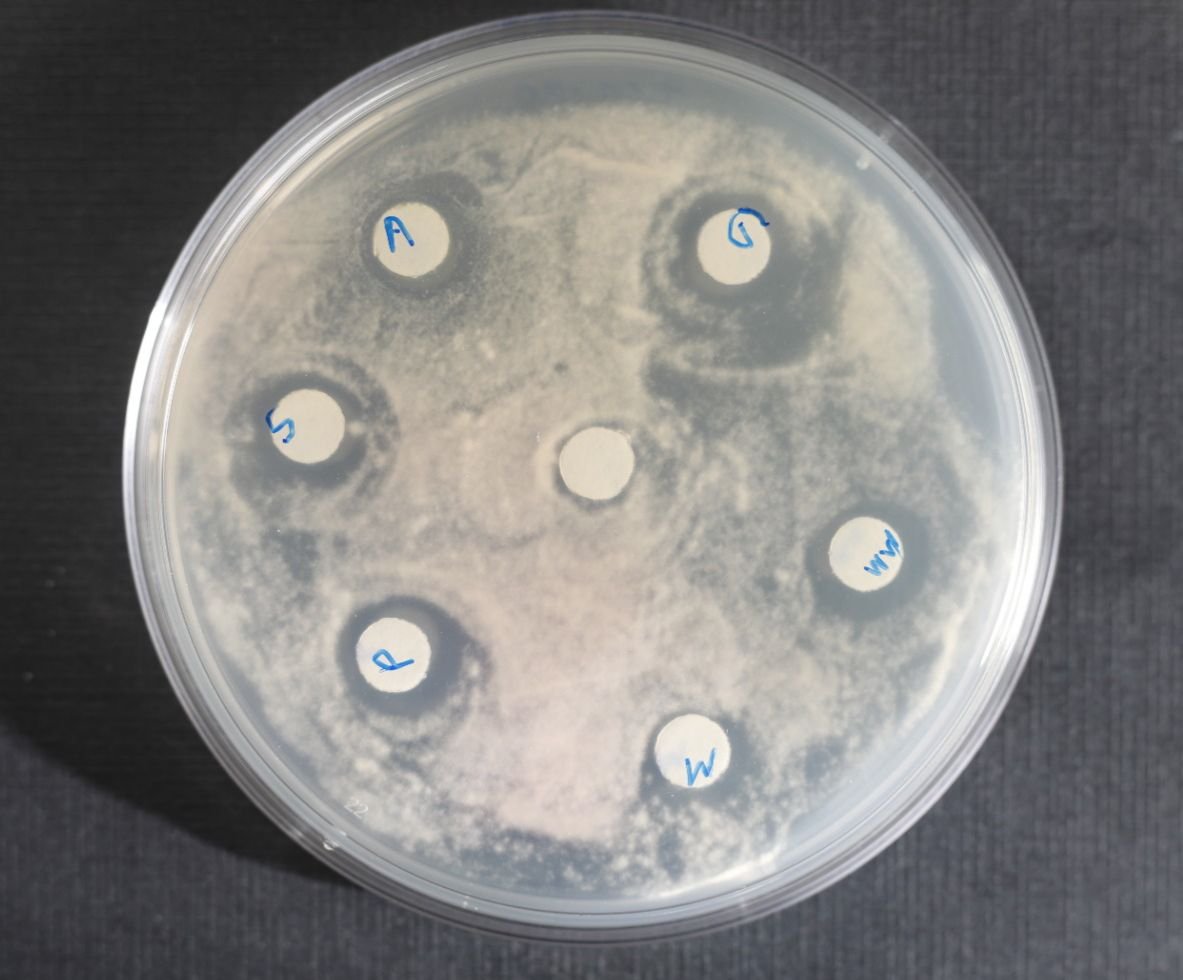
Venoms Research

About Me
Researcher | Biologist | Academic

Welcome to my website! I'm a biologist and researcher, currently pursuing my PhD in Evolution, Ecology and Organismal Biology at The Ohio State University (OSU - Columbus, OH), United States.
My research focuses on social immunity and adaptations of fungus-growing insects toward pathogenic microbes. I seek evidence of adaptive social immunity in fungus-growing ants (collective immune memory) and investigate which mechanisms could be involved when recognizing microbes. I also strive to understand the role of venoms in social immunity and how social parasites impact the group-level defenses of hosts.